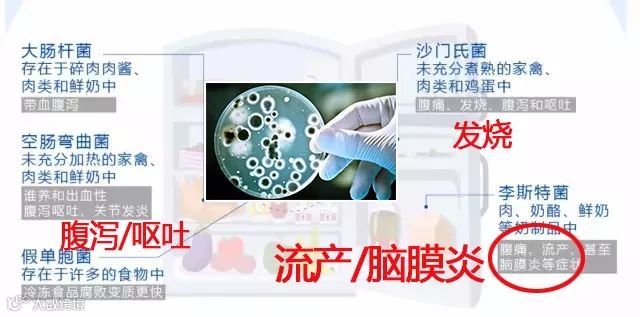

夏日炎炎,不仅人怕热坏了,我们吃的食物也怕变质。
在大家一贯认知里,把各种生食、熟食、蔬菜、水果塞进冰箱就可以很好地保存食物,认为低温就很安全。

但冰箱虽然能保鲜,却没有“杀菌”作用。
再怎么干净的冰箱用上几天,每打开一次冰箱,总会有异味。

不知名的异味是冰箱里的蔬菜食物在细菌的分解下发生的氧化反应,才生成刺激难闻的气体!

据调查,63.3% 的家庭 5 年以上末对冰箱内部进行清洗,96.7% 的家庭从未对冰箱进行过消毒处理。
并且这几年“冰箱病”频繁上新闻,家里的小孩和老人吃了被细菌感染的食物,很容易生病,拉肚子。随便去趟医院都要千八百的,真是伤不起。

家居里受灾的不仅仅是冰箱,打开衣橱,也总有股说不清的奇怪味道;
打扫再干净的厕所,臭味依旧让人皱眉;
鞋柜里混合着脚汗味和皮革味,还有就是新买的家具,其中潜藏了许多致癌的甲醛……

为了消除这些异味,我也是想了很多方法,结果都不太如人意,甚至还起了反作用。
放橘子皮、茶叶包效果比较差,还容易腐烂滋生细菌;
活性炭的吸附力强,但寿命极其短,如果没能及时更换,容易造成二次污染。

有没有使用方便简单,除味又杀菌,关键还能长期使用的除味产品呢?
最近让我找到了一个有效又省力的消毒杀菌方法,就是这颗Q萌的马卡龙“蛋蛋”——家家恋魔蛋除味宝。
第一次看到这个产品的时候,就被它萌萌的外表吸引了~

大小跟一颗蛋差不多,清新简单的色调,加上可爱又调皮的表情简笔画,简直就是一件装饰品嘛。
使用后我才发现这个小巧可爱的魔蛋不仅有除臭,杀菌还有保鲜等功能,而且能够重复使用至少五年!
哪里有异味就放哪里,循环使用,实在是性价比超高的家居必备神器!
家家恋魔蛋除味宝
规格:4个/盒
特惠价:59元
点击下图即可购买▼
抗菌、除臭、保鲜全搞定,
1颗=500包活性炭
你知道么,当我们把食物放冰箱冷藏2小时后,细菌就会开始疯狂裂变,不到一天细菌数就上千万了。
冰箱的低温会使抗冻耐冷型的细菌获得更适宜的生存环境。

而且这种细菌也是冰箱里异味产生的源头。
想要除味,首先要杀菌!这颗除味蛋就是专治各种“冰箱病”的。
我们做了一个实验,把除味蛋放进冰箱,隔天冰箱里的异味就明显消除了。
除味蛋同时还能避免食物之间的互相串味,食物放进去不会沾染一丝的冰箱臭味。
它是利用活性炭成分吸附异味,有效杀死大肠杆菌等有害细菌,保证我们的食品安全。

除味蛋还有一个隐藏技能——锁鲜!能减缓食材新陈代谢的速度,让保鲜期延长3倍!
我们通过实验可以看到,把米饭分别放在有、无除味蛋的冰箱中,1周后,普通冷藏室的米饭已经变质,另一边还很新鲜!

大家都知道苹果是最容易氧化的,为了再次验证效果,我们这次拿来了半个切开的苹果。1天后,放有除味蛋冰箱里的苹果,明显要更新鲜!

一个小小的魔蛋的除臭能力,约等于500包活性炭,把细菌异味统统秒杀。
从此打开冰箱,每一口呼吸到的都是健康的味道。

特殊材质,除味能力强
有的家庭喜欢放置香型的除味剂,这些香味都是化学合成物,长期吸入对身体有害,而且完全达不到除湿抑菌的作用。

家家恋魔蛋除味宝采用天然优质硅藻土+活性竹炭制作而成。
被誉为“东北第四宝”的长白山天然硅藻土,具有强效除湿、除臭力,同时还有消毒杀菌功能!

科学研究表明,硅藻土对有害气体的吸附能力是活性炭的5000倍!它通过保持干爽,破坏细菌生长的温床,起到抑菌防霉的作用。

以“黑色维他命”著称的活性竹炭是国际公认的吸毒能手!特殊的多孔隙结构,可以更大程度的接触空气,吸附有害气体,异味细菌通通逃不了!
除了能让杀菌效果如虎添翼,而且没有任何有害物和残留产生,是非常安全健康的杀菌成分。
它的吸附性到底有多牛,我们看看试验就知道了。

这是吸烟尘能力,一转眼,就将烟雾吸得干干净净,除味功能超厉害。整个空间干干爽爽自然就不会再滋生细菌。

家家恋魔蛋除味宝
规格:4个/盒
特惠价:59元
点击下图即可购买▼
小身材,随处可放,
能反复使用至少5年
魔蛋除味宝跟一颗鸡蛋差不多大,可放置家中任何位置,吸取不同空间的异味,
除了冰箱之外,还能放卫生间和衣柜里,蛋蛋就像海绵一样吸收着异味,还你一个自然清闲的居家环境。

长期散发臭味的鞋柜,放一颗鞋柜香喷喷,再也不怕有异味了!

这颗魔蛋可以反复使用,只需定期晾晒就可以了,一次购买,可长达五年使用,成本低到令人尖叫!超划算!

权威检测验证,安全可靠
一个商品健康安全才是最重要的。家家恋魔蛋除味宝经过了严格的安全检测,完全符合标准,可以放心使用。

一共有五个颜色可选,马卡龙色系,使用的时候心情都变好了。

今天我们向品牌方要来了最大优惠,某宝单个26元,而我们限时活动买一盒(一盒4颗)仅需59元,价格便宜近一半!

家家恋魔蛋除味宝
规格:4个/盒
特惠价:59元
点击下图即可购买▼

平时剥完鱼虾、大蒜、洋葱,手上的味儿你会用香皂或洗手液洗吗?
这些味道一般的清洁产品很难彻底将这些异味洗掉。
那么我们就需要一个黑科技的皂了!ECHO纳米去味钢皂,堪称去异味神器!

那不锈钢肥皂究竟为什么能够除异味呢?
原理在于,用纳米钢皂洗手时,表面产生正荷电,手上附着的异味分子(负电)就会被魔术肥皂吸走。异味随着流水也就消失了。

它不仅可以用在厨房里除异味,还可以放在冰箱里当做冰箱除臭剂,去除宠物窝、装修等异味,甚至腋臭、脚臭的异味也能消除。

把不锈钢肥皂一半浸泡在水中,或用湿毛巾包裹放入冰箱,就能去除异味。
不过不能放在冷冻区,以免失效。
现在给大家争取到特惠价,高科技纳米去味钢皂仅需29元。
点击下图即可购买▼
温馨提示
任何购物及售后问题咨询,可在购买页面直接联系商城客服,或者添加好物专属客服微信:健康是大大。
 也欢迎加入我们的好物粉丝群
也欢迎加入我们的好物粉丝群
入群后,你可以:
直接与客服或小编对话,解答购物过程中遇到的任何问题
获取内部优惠券或专属折扣
参与抽奖活动或粉丝答谢活动,赢取礼品
提出任何意见、建议、反馈,或者不满、吐槽
好物客服微信在这里!
如果想入群,请备注:好物入群




订单、物流查询:
点击文中任一小程序购买图标,进入家医优选好物店铺首页,点击右下角“个人中心”即可查看。











